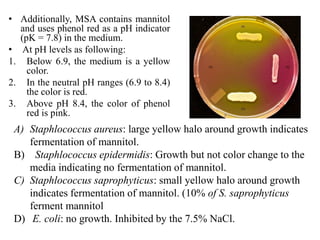
• Additionally, MSA contains mannitol
and uses phenol red as a pH indicator
(pK = 7.8) in the medium.
• At pH levels as following:
1. Below 6.9, the medium is a yellow
color.
2. In the neutral pH ranges (6.9 to 8.4)
the color is red.
3. Above pH 8.4, the color of phenol
red is pink.
A) Staphlococcus aureus: large yellow halo around growth indicates
fermentation of mannitol.
B) Staphlococcus epidermidis: Growth but not color change to the
media indicating no fermentation of mannitol.
C) Staphlococcus saprophyticus: small yellow halo around growth
indicates fermentation of mannitol. (10% of S. saprophyticus
ferment mannitol
D) E. coli: no growth. Inhibited by the 7.5% NaCl.

1. The document discusses different types of culture media used to grow microorganisms in the laboratory, including solid media, semisolid media, and liquid broths.
2. Solid media like agar plates are used for isolating pure cultures, observing colony morphology, and storing cultures long-term. Semisolid media allow studying bacterial motility.
3. Broths are used for growing cultures for assays and biochemical tests since bacterial growth is visible through turbidity.
4. Agar is commonly used to solidify media due to its properties of being bacteriologically inert and allowing surface growth of colonies.